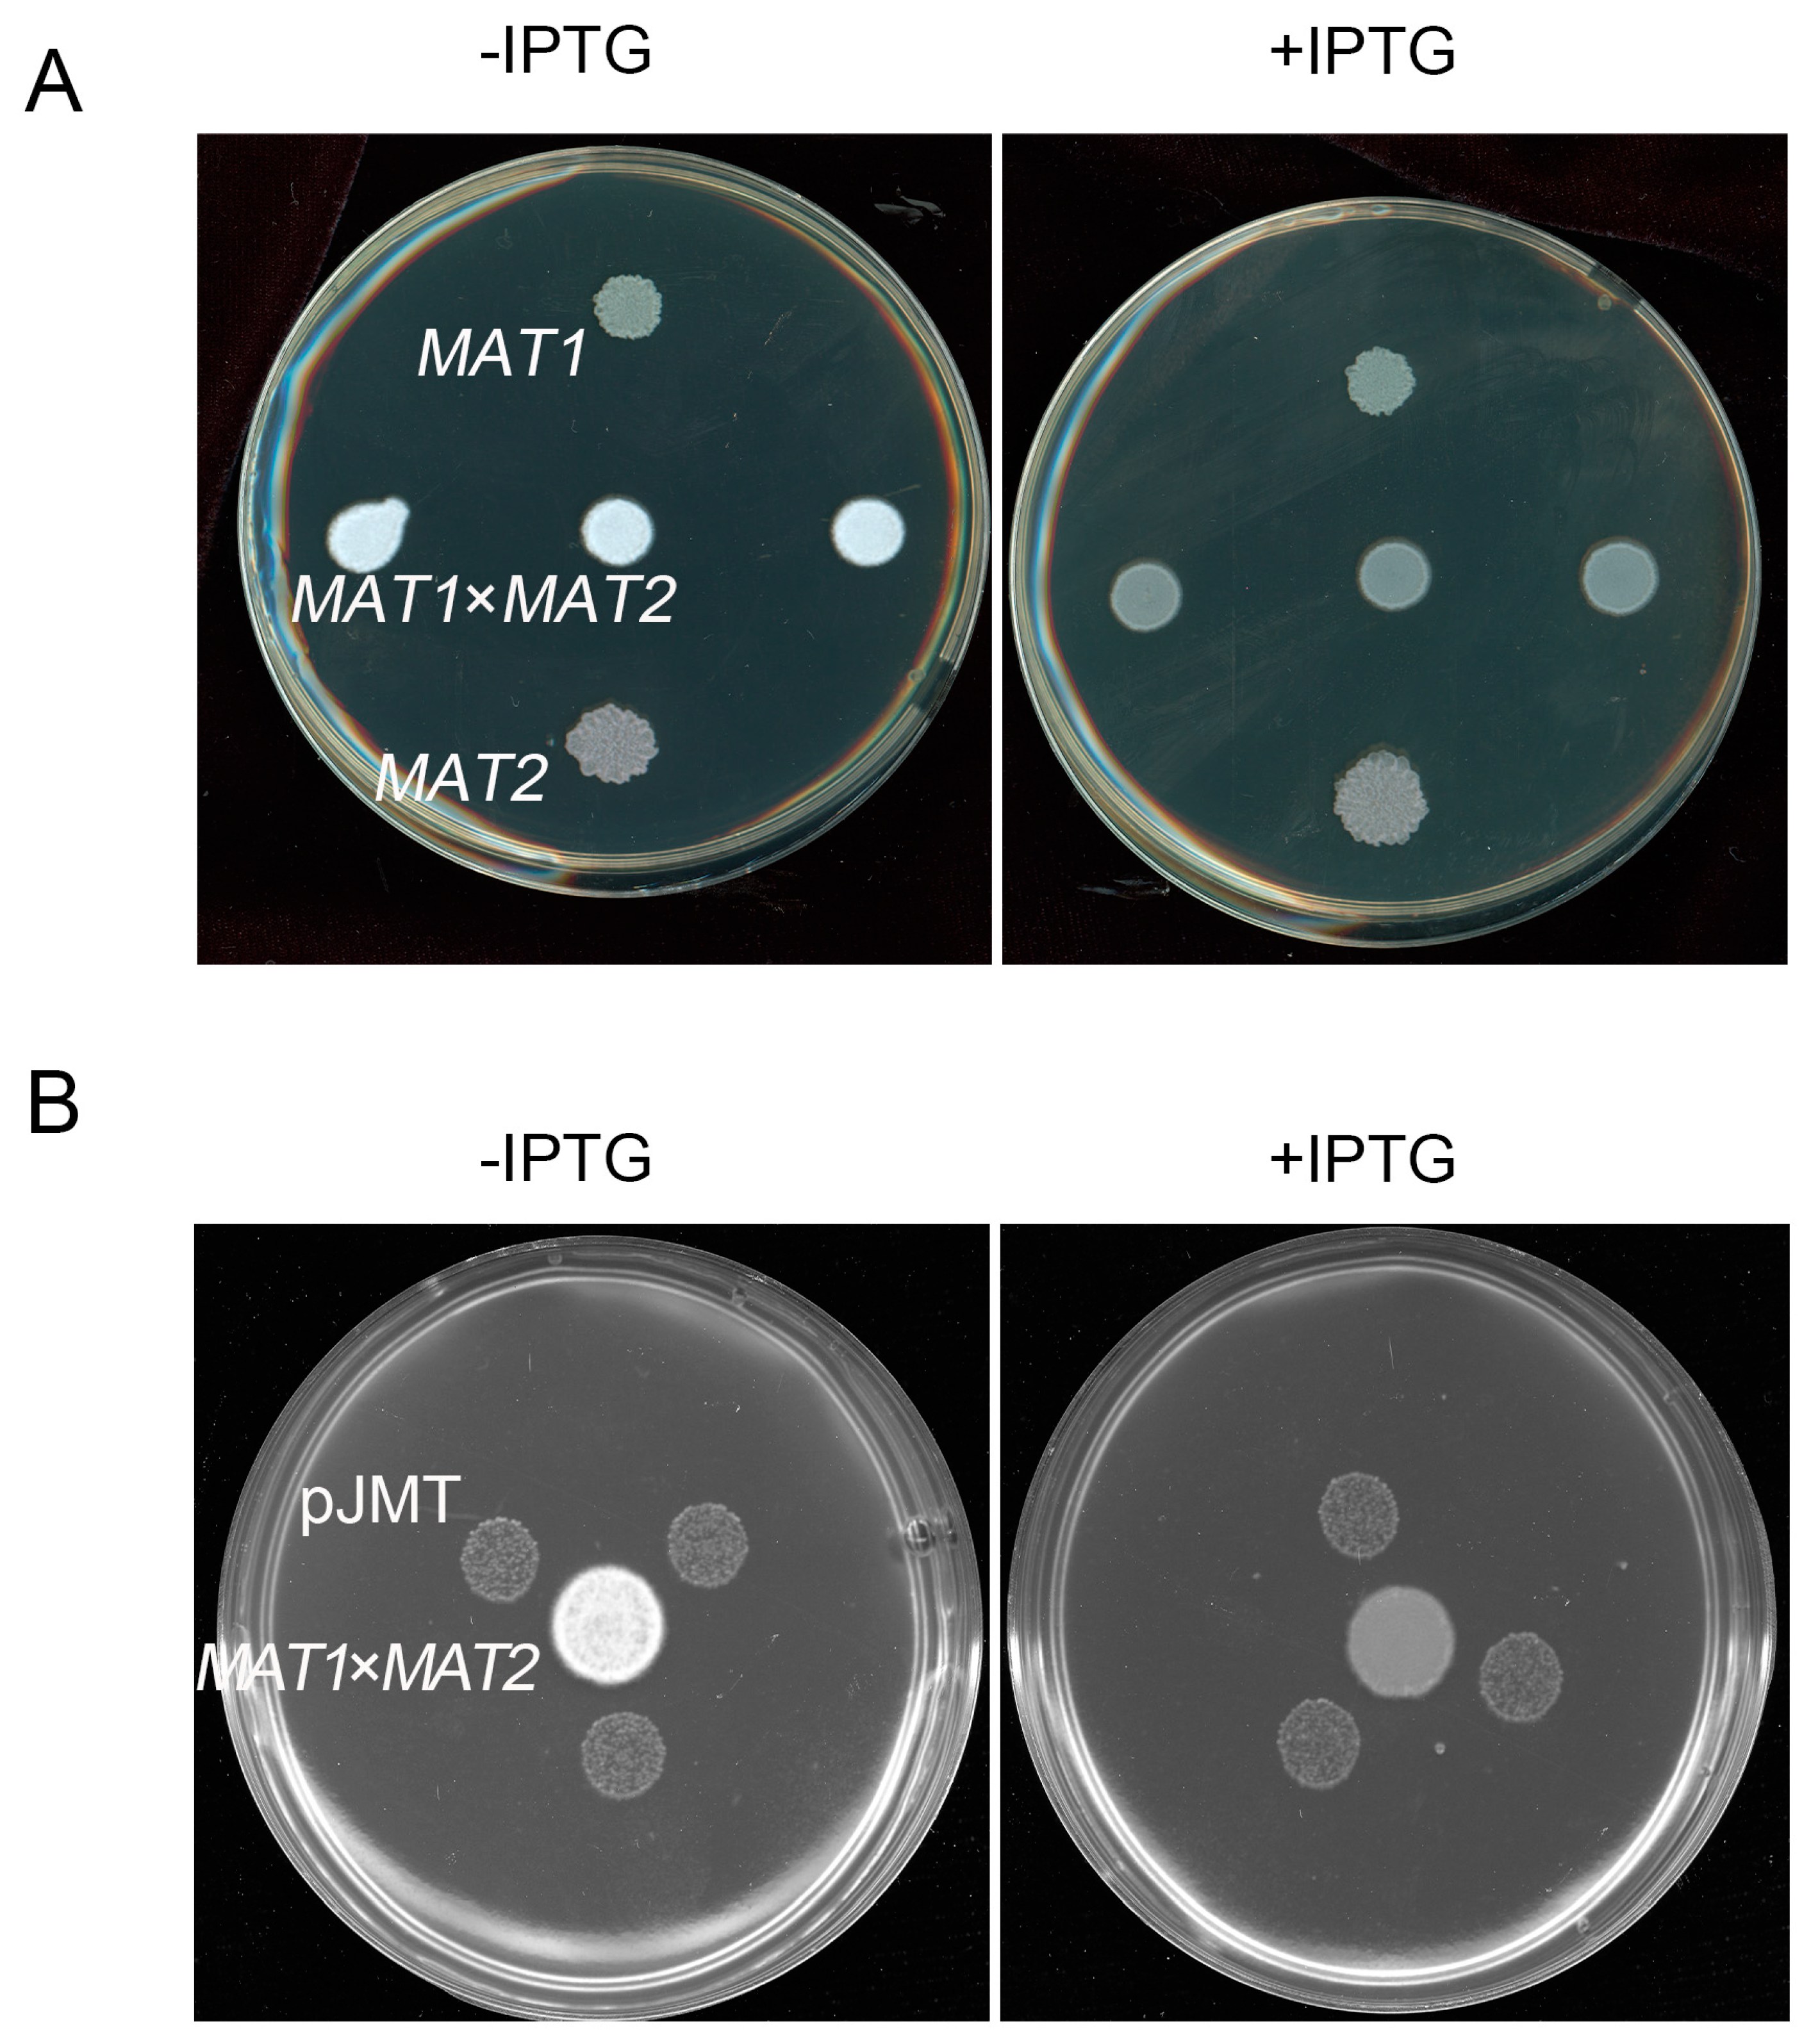

1. Introduction
Sporisorium scitamineum is the fungal pathogen causing sugarcane smut [
1]. Diploid teliospores of
S. scitamineum are airborne and can survive in harsh environmental conditions. The smut teliospores germinate on sugarcane buds, forming promycelium from which two pairs of haploid sporidia (basidiospores) with opposite mating-types,
MAT-1 and
MAT-2, are generated via a round of meiosis. Sporidia of opposite mating-types can recognize each other and fuse, undergoing sexual mating, afterwards switching from yeast-like growth style to dikaryotic hyphae, so-called dimorphic switch. Dikaryotic hyphae are capable of infecting sugarcane, likely through buds. The smut disease symptom is characterized by the emergence of a typical structure produced on the apex or side shoots of sugarcane stalks, called “smut whip”, which contains teliospores formed from fusion of two nuclei of the dikaryotic hyphae [2, 3].
Given that post-mating dimorphic switch is critical for host infection, molecules controlling this step are potential disease management targets. The mechanisms of sexual mating and pathogenicity of smut fungi were well studied on the model fungus
Ustilago maydis [
4]. The progresses of infection and sexual mating are similar in smut fungus, and the research on
U. maydis provides an important reference for
S. scitamineum [
5]. Different mating types are determined by two alleles, named
MAT loci include a locus and b locus, in
S. scitamineum and
U. maydis [
5]. In
S. scitamineum, the
MFA genes of the mating locus a locus encode pheromone precursors (including a factor and α factor), which undergo a series of post-translational modifications and are secreted out of sporidial cells, serving as signaling molecules [6-8]. The a or α pheromone is recognized by the pheromone receptor Pra, of the opposite-mating type, which transmits the signal into the cell, and through the MAPK or cAMP-PKA signaling cascades to the global transcriptional factor Prf1, which in turn induces dikaryotic hyphae growth via activating a and b locus [8-11]. The conserved farnesyltransferase (FTase) β subunit SsRam regulates yeast-to-hyphae dimorphic switch, stress resistance and pathogenicity of
S. scitamineum, likely via catalyzing farnesylation of the pheromone precursor Mfa1 [
8]. Besides conveying the sexual pheromone signal, the MAPK SsKpp2 and SsHog1 are involved in the response to extracellular osmotic stress, and thus regulate the dimorphic switch and stress resistance [9, 11]. Investigation of molecular mechanism underlying
S. scitamineum dimorphic switch/filamentous growth would provide a theoretical basis for developing novel and effective management strategies of sugarcane smut, which is largely lacking and urgently needed in agricultural practice.
Jasmonic acid (JA) and its methylated product, methyl jasmonate (MeJA), are important phytohormones playing an important role in plant resistance to biotic and abiotic stresses [
12]. MeJA treatment with the tomato before sowing can reduce the attack of the soil-born fungal pathogen
Fusarium oxysporum f.sp. lycopersici [
13]. Endogenous MeJA content of plants increases significantly in response to mechanical damage, pathogen infection, ozone and metal stress in
Brassica napus L [
14]. In
Arabidopsis thaliana, gaseous MeJA can effectively reduce the harm caused by fungal pathogens
Alternaria brassicicola,
Botrytis cinerea or
Plectosphaerella cucumerina [
15]. Jasmonic acid carboxyl methyl transferase (JMT) catalyzes MeJA formation by using JA as a precursor [
16].Over-expression of
AtJMT in
A. thaliana induces the constitutive expression of JA biosynthesis-related genes and confers enhanced resistance towards the fungal pathogen
B. cinerea [
17]. Rice
OsJMT gene is induced by infestation with brown planthopper (
Nilaparvata lugens), catalyzing JA to MeJA and thus regulating herbivore-induced defense responses [
18]. Taken together, enhanced level of MeJA by JMT function can confer plant immunity against pathogenic fungi and pests.
In this study, MeJA displayed a significant inhibitory effect on S. scitamineum mating/filamentation, while JA did not. Through heterologous expression of A. thaliana JMT gene in the E. coli strain, we generated a strain, designated as pJMT strain, capable of converting JA to MeJA under in vitro culture condition. To test the capacity of pJMT strain in controlling smut disease, we applied it to maize or sugarcane plants exposed to smut fungi (U. maydis and S. scitamineum) respectively. Application of pJMT strain to maize seedlings grown in pots could significantly improve the ability of maize to resist the occurrence of smut disease. In summary, enhancing plant resistance to pathogens by microbes-dependent phytohormone biosynthesis may serve as a biological control method pending necessary optimization for utilization in field condition.
2. Materials and methods
2.1. Fungal strains and culture conditions
The
S. scitamineum strains
MAT-1 (eGFP) and
MAT-2 (dsRED) used in this study were generated by Yan et al. [
19], and stored in Deng Y’s lab. The haploid
MAT-1 (U9) and
MAT-2 (U10) strains of
U. maydis were provided by Jiang Z’s lab. The
S. scitamineum and
U. maydis sporidia were cultured in YePS medium [
19], and the sexual mating medium of
U. maydis was YePS medium supplemented with 1% activated carbon. Fungal cells were cultured in 2 mL YePS medium at 28° C, shaking at 200 rpm for 2 days, then collected by centrifugation and washed with 2 mL sterilized water, before re-suspend in sterilized water to reach OD
600≈ 1.0. Equal volume of
S. scitamineum or
U. maydis sporidia, of opposite mating-types, were mixed to induce sexual mating and the following filamentous growth. For suppression assay, sporidia of wild-type
MAT-1 and
MAT-2 sporidia of
S. scitamineum (OD
600=1.0 for both) were mixed (1 μl for each) and allowed to grow on YePS solid medium containing JA or MeJA of different concentrations. Filamentation of the fungal colonies was assessed visually, and the experiments were repeated by three time.
2.2. Construction of JMT expression plasmid
The
A. thaliana JMT (GeneBank: AY008435.1) nucleotide sequence was synthesized by Suzhou Genewiz Biological Technology Co., Ltd. (Suzhou, People’s Republic of China), and inserted into the
EcoR I-
Sal I site of the expression vector pRSFDUET-1 [
20]. The expression plasmid was transformed into
E. coli BL21(DE3) strain, and verified by PCR amplification using the primers as listed in
Table 1.
2.3. Total RNA extraction and quantitative real-time PCR (qRT-PCR)
RNeasy Mini Kit (Qiagen, 74104) was used for total RNA extraction. TURBO DNA-free Kit (Invitrogen, AM1907) and TransScript First-Strand cDNA synthesis supermix (Transgen, AT301) were respectively used for gDNA removal and first strand cDNA synthesis, following manufacturer’s instructions. PowerUp SYBR green master mix (Applied Biosystems, A25742) was used for qRT-PCR, with the primers as listed in
Table 1, and the reaction was run on QuantStudio 6 Flex Real-Time PCR system (Thermo Fisher Scientific). Relative expression folds were calculated by the 2
−ΔΔCT method [
21] with
ACTIN as an internal control. Statistical analysis was performed by one-way ANOVA and Duncan’s multiple analysis.
2.4. JMT gene induction
Induced expression of JMT gene: the pJMT-carrying strain (hereafter named as pJMT strain) was cultured in 5 mL LB borth containing 50 μg/mL kanamycin (Dingguo, AK177), at 37 °C and shaking at 200 rpm, till OD600≈ 1.0. Isopropyl β-D-Thiogalactoside (IPTG, Genview, CI175) was added to the pJMT strain culture to reach the final concentration of 1 mM, and cultured at 28 °C and 200 rpm for another 12 h. The bacterial cells were collected by centrifugation at 1000 × g and transferred to 50 mL of LB medium containing 200 μM jasmonic acid (JA, Sigma, J2500) and 200 μM S-adenosyl-L-methionine (SAM, Sigma, A4377), and incubated at 28 °C, 200 rpm for 12 h. The E. coli strain expressing the vector pRSFDUET-1 was used as a negative control.
2.5. MeJA or JA detection
For extract of MeJA from the induced pJMT strain cultured in presence of JA and SAM, the supernatant was collected after centrifuge and mixed with ethyl acetate of equal volume. After phase separation, ethyl acetate phase was collected and dried by rotary evaporation (EYELA, OSB-2100). Such extracts were dissolved in 1 mL of methanol and filtered through a 0.22-μm PVDF membrane (Nylon6). For detection of JA from the extracts, high performance liquid chromatography (HPLC) was performed using the following settings: 0.1% formic acid: water= 65/35 (V/V), flow rate= 0.3 mL/min, detection wavelength= 205 nm, detection time= 20 min, and column temperature= 30 °C. The column is Agilent HC-C18(2) 250 × 4.6 mm (5 μm).
MeJA was identified by Gas Chromatography/Mass Spectrometry (GC/MS) on an Agilent 7890B/5977B (Agilent Technologies Inc., Santa Clara, CA, USA) Series GC System equipped with an Agilent HP-5MS capillary column (30 m × 250 µm × 0.25 µm) in scan mode and split mode. The following temperature program was used: initial temperature of 60 °C (5-min hold), increase to 270 °C at 30 °C/min. Ion source temperature was 220 °C, and transfer line temperature was 270 °C. Electron ionization energy was 70 eV, and m/z= 30 ~ 450. MeJA was identified through standard compounds from the National Institute of Standards and Technology (NIST, Gaithersburg, MD, USA) library database.
2.6. Pathogenicity assays
Pot experiment: Maize (Hua Meitian 9; DYQS-16×TG-9) was grown in pots till four-leaf stage, under the growth condition set as follows: humidity: 82 %; light duration: 12 hours. The mixed U. maydis MAT-1 and MAT-2 cells (OD600≈ 1.0, 1:1 in volume), with or without 400 μM MeJA, were injected to the base of maize leaves. Injection with sterile water served as blank control. The injected maize seedlings were allowed to grow under natural conditions for 3 weeks, before examination of disease symptoms and photographing. Testing pJMT strain’s effect on maize smut disease following the same procedure. The pJMT strain was pre-treated with IPTG to induce expression of JMT gene.
Field experiment: Approximately 290 seedlings of ratoon cane (ROC22) were used for pJMT treatment, or untreated as control, respectively. The sugarcane cultivar ROC 22 is established as a susceptible cultivar towards smut fungus, as reported [
22].The pathogenicity and biocontrol assay was carried out on an established diseased field (Experimental fields of South China Agricultural University, 23.23 E, 113.63 W), which steadily causes smut disease to the susceptible cane (ROC22) to a rate of above 20%. The tested canes are 3rd year ratoon canes. Application of pJMT was performed within 3 days after cutting off the above-ground part of the canes. following the established procedure [
23].
4. Discussion
Sugarcane smut caused by
Sporisorium csitamineum is considered as the most serious and widespread disease of sugarcane [
2], severely affecting sugarcane yield and quality, and thus causing significant economic loss [26-28]. The disease control methods for sugarcane smut include physical control, fungicide control and disease-resistant breeding [29-31]. The application of fungicides is not only expensive, but also leads to serious environmental pollution problem, and drug-resistance of the pathogens, with increasing fungicide dosage in pursuit of control effects. Although disease-resistant breeding is the most effective method to control sugarcane smut in agricultural practice, the breeding process of disease-resistant varieties is difficult and time-consuming [32, 33], and the fast-evolved pathogen races cause the loss of resistance of disease-resistant varieties [
34]. At present, highly efficient, sustainable and environment-friendly control strategy for sugarcane smut is still lacking, and in urgent need.
Phytohormones not only regulate plant growth, but also participate/regulate plant immune responses to pathogens. Auxin regulates plant cell division, enlargement and differentiation [
35]. Exogenous addition of auxin increases the tolerance of
Medicago truncatula to
Macrophomina phaseolina infection [
36], indicating a positive regulation of plant immunity. In
Arabidopsis thaliana, exogenous addition of auxin affects the proliferation of
Pseudomonous syringe [
37], but does not affect
Fusarium oxysporum [
38]. Salicylic acid (SA) and jasmonic acid (JA) are important defense hormones. Necrotrophic pathogens can activate JA-related defense responses [
39]. SA plays an important role in defending against infection by biotrophic and hemibiotroph pathogens [
40]. Moreover, as plant hormone, SA can interact with a variety of plant hormone-related signaling pathways to activate the immune response and disease resistance of plants [
41]. Application of MeJA to roots or foliar tissues can enhance transcriptional expression levels of resistance genes in sugarcane towards various classes of soil-borne pests and pathogens [
42]. MeJA increases plant resistance by regulating antioxidant defense systems in sugarcane seedlings [
43],
Panax ginseng C.A. Mey. roots [
44], and
Glycine max L. leaves [
45]. Furthermore, foliar application of MeJA could improve the grape and wine quality [
46].
In this study, we found that the phytohormone MeJA could inhibit the dimorphic transition, a critical step in pathogenic development, of smut fungi
S. scitamineum and
U. maydis (
Figure 1,
Figure 2A). It is interesting to notice that MeJA inhibits
S. scitamineum sexual mating while causing a significantly increase in the transcriptional levels of the mating types genes, pheromone genes mfa1/2 and pheromones receptor gene pra1/2. We infer that suppressed transcription of b loci genes is more important for regulating filamentation, which is inhibited by MeJA. Up-regulation of the a loci genes doesn’t guarantee promoted sexual mating, as the encoded pheromone peptides need post-translational modification [
47] for activation, and the pheromone receptors Pra1/2 need to recognize the activated pheromone peptide from the opposite mating-type [
48]. Besides, we noticed that limited difference in transcription of the a and b loci genes in presence of MeJA, which would almost completely suppress mating/filamentous growth. We hypothesis that besides suppression on a and b loci gene transcription, MeJA may target other pathway critical for filamentation of
S. scitamineum, which was not identified in this study.
Furthermore, we found that exogenous addition of MeJA suppressed disease symptom (tumors formation) caused by
U. maydis infection to maize seedlings, under pot experiment (
Figure 2B). The pJMT strain, hetrogenously expressing the plant
JMT gene, was able to catalyze MeJA production using JA as a precursor (
Figure 3). Although under in vitro culture condition, formation of
S. scitamineum dikaryotic hyphae could be effectively inhibited by confrontation or by supplying the supernatant of pJMT culture (
Figure 4), suggesting that such MeJA-producing pJMT strain could be potentially used as a biocontrol agent against smut disease caused by the fungal pathogens. However, direct application of this pJMT strain to the infected maize or sugarcane seedlings, in pot experiment or in field experiment, did not show obvious disease control ability (
Figure 5 and
Figure 6). When performing the pot and field experiments, we pre-treated the pJMT culture with IPTG to induce JMT expression. Possible reasons for the failure of pJMT strain in smut disease control may include, that the symptom development process in the field is long and complicated. In future, we would like to further modify this strain by using a strong, constitutive, and native promoter of
E. coli to drive JMT gene. Alternatively, a pathogen-inducible promoter would be screened and tested.
At present this pJMT construct showed no capacity in suppressing smut disease either in maize (pot condition) or sugarcane (field condition). But the idea is that a bacteria strain expressing JMT gene that could utilize plant-source JA to facilitate MeJA production, which was shown to suppress dikaryotic hyphae growth of smut fungus in this study. Future attempts will be conducted to monitor and enhance the colonization ability and/or strain stability of pJMT strain, with the aim to develop it as a useful tool in prevention and management of smut disease.
Figure 1.
MeJA suppressed S. scitamineum dikaryotic hyphae growth after sexual mating. A: The
MAT-1 (
eGFP) and
MAT-2 (
dsRED) sporidia were cultured in liquid YePS medium for 2 d and adjusted to OD
600≈ 1.0, before mixed as 1:1 ratio and inoculated on YePSA or MM-N medium containing the indicated chemicals of various concentrations. The mating cultures were kept in dark, 28 °C, for 5 d before photographing.
MAT-1 sporidia were spotted in the upper panel, while
MAT-2 in the lower panel, of each plate. Three colonies in the middle of each plate are the mixed
MAT-1 and
MAT-2 sporidia to induce mating and filamentation. B: Microscopic observation of fluorescent protein-tagged
S. scitamineum MAT-1 and
MAT-2 sporidia [
19] during sexual mating/filamentous growth, using ZEISS Observer Z1. Arrows denote un-mating sporidia, under MeJA treatment. Scale bars= 20 μm. C: qPCR analysis to assess transcription of a locus gene
MFA 1/2 and
PRA 1/2, and b locus
BE 1/2 and
BW 1/2 during
S. scitamineum filamentation with or without MeJA treatment. The 1:1 ratio mixed
MAT-1 and
MAT-2 sporidia were allowed to grow on YePS medium under 28 °C, for 2 d, before total RNA extraction and qRT-PCR analysis. Relative gene expression level was calculated by the 2
−ΔΔCT method [
21] with
ACTIN as an internal control. Primers used for transcriptional profiling were listed in
Table 1. Statistical analysis was performed by one-way ANOVA and Duncan’s multiple analysis. Different letters indicate significant differences, n= 3. Methanol (20 μL per 40 mL medium) served as solvent control in (A)-(C). The experiments were repeated by three time.
Figure 1.
MeJA suppressed S. scitamineum dikaryotic hyphae growth after sexual mating. A: The
MAT-1 (
eGFP) and
MAT-2 (
dsRED) sporidia were cultured in liquid YePS medium for 2 d and adjusted to OD
600≈ 1.0, before mixed as 1:1 ratio and inoculated on YePSA or MM-N medium containing the indicated chemicals of various concentrations. The mating cultures were kept in dark, 28 °C, for 5 d before photographing.
MAT-1 sporidia were spotted in the upper panel, while
MAT-2 in the lower panel, of each plate. Three colonies in the middle of each plate are the mixed
MAT-1 and
MAT-2 sporidia to induce mating and filamentation. B: Microscopic observation of fluorescent protein-tagged
S. scitamineum MAT-1 and
MAT-2 sporidia [
19] during sexual mating/filamentous growth, using ZEISS Observer Z1. Arrows denote un-mating sporidia, under MeJA treatment. Scale bars= 20 μm. C: qPCR analysis to assess transcription of a locus gene
MFA 1/2 and
PRA 1/2, and b locus
BE 1/2 and
BW 1/2 during
S. scitamineum filamentation with or without MeJA treatment. The 1:1 ratio mixed
MAT-1 and
MAT-2 sporidia were allowed to grow on YePS medium under 28 °C, for 2 d, before total RNA extraction and qRT-PCR analysis. Relative gene expression level was calculated by the 2
−ΔΔCT method [
21] with
ACTIN as an internal control. Primers used for transcriptional profiling were listed in
Table 1. Statistical analysis was performed by one-way ANOVA and Duncan’s multiple analysis. Different letters indicate significant differences, n= 3. Methanol (20 μL per 40 mL medium) served as solvent control in (A)-(C). The experiments were repeated by three time.

Figure 2.
MeJA suppressed U. maydis sexual mating/filamentation. A: The MAT-1 and MAT-2 sporidia of OD600≈ 1.0 were mixed as 1:1 (V/V) and inoculated on the YePSA medium containing MeJA (400 μM) or methanol (20 μL per 40 mL medium; solvent control). The mating cultures were kept in dark, 28 °C, for 5 d before photographing and microscopic observation. Scale bar= 20 μm. B-D: Mixed U. maydis sporidia (1 mL; OD600≈ 1.0; MAT-1: MAT-2= 1: 1, V/V), with or without MeJA (400 μM) treatment, were injected to maize seedlings at four-leaf stage (Hua Meitian 9; DYQS-16×TG-9). Injection with water served as blank control. The injected seedlings were allowed to grow in pots under natural condition for 21 d, before photographing of the tumor symptoms, as denoted by the arrows. The histogram was drawn by GraphPad Prism (Version: 8.0.2). The experiments were repeated for three time, containing at least 23 seedlings for each treatment. Significant differences in no-symptom plants between U. maydis infected seedlings with or without MeJA treatment were determined by a two-tailed Student’s t-test (*p = 0.0175).
Figure 2.
MeJA suppressed U. maydis sexual mating/filamentation. A: The MAT-1 and MAT-2 sporidia of OD600≈ 1.0 were mixed as 1:1 (V/V) and inoculated on the YePSA medium containing MeJA (400 μM) or methanol (20 μL per 40 mL medium; solvent control). The mating cultures were kept in dark, 28 °C, for 5 d before photographing and microscopic observation. Scale bar= 20 μm. B-D: Mixed U. maydis sporidia (1 mL; OD600≈ 1.0; MAT-1: MAT-2= 1: 1, V/V), with or without MeJA (400 μM) treatment, were injected to maize seedlings at four-leaf stage (Hua Meitian 9; DYQS-16×TG-9). Injection with water served as blank control. The injected seedlings were allowed to grow in pots under natural condition for 21 d, before photographing of the tumor symptoms, as denoted by the arrows. The histogram was drawn by GraphPad Prism (Version: 8.0.2). The experiments were repeated for three time, containing at least 23 seedlings for each treatment. Significant differences in no-symptom plants between U. maydis infected seedlings with or without MeJA treatment were determined by a two-tailed Student’s t-test (*p = 0.0175).

Figure 3.
E. coli pJMT strain was able to convert JA to MeJA under in vitro culture condition. (A) Detection of JA by HPLC. The region in the dashed box denotes JA, detected as retention time=18.5 min, wavelength= 205 nm. Green line denotes JA standard, while red line and green line respectively as supernatant extracted from the pJMT culture with or without IPTG induction. Peak area for green line is 107510.0, and is 1815.1 for red line. (B) Schematic representation of pJMT catalyzing conversion of JA to MeJA, under in vitro culture condition.(C) GC-MS analysis to detect JA and MeJA from supernatant of the pJMT culture without IPTG induction (upper panel) or under IPTG induction (lower panel).
Figure 3.
E. coli pJMT strain was able to convert JA to MeJA under in vitro culture condition. (A) Detection of JA by HPLC. The region in the dashed box denotes JA, detected as retention time=18.5 min, wavelength= 205 nm. Green line denotes JA standard, while red line and green line respectively as supernatant extracted from the pJMT culture with or without IPTG induction. Peak area for green line is 107510.0, and is 1815.1 for red line. (B) Schematic representation of pJMT catalyzing conversion of JA to MeJA, under in vitro culture condition.(C) GC-MS analysis to detect JA and MeJA from supernatant of the pJMT culture without IPTG induction (upper panel) or under IPTG induction (lower panel).
Figure 4.
E. coli pJMT strain suppressed S. scitamineum filamentation under in vitro culture condition. The pJMT strain was able to suppress filamentous growth of S. scitamineum after sexual mating, by supplying the supernatent to the fungal colonies (A), or in confrontation assay (B). A: JA was added in the liquid LB to reach a final concentration of 200 μM, with or without IPTG (1 mM) to induce JMT induction. 4mL supernatant of pJMT culture were mixed with 6 mL YePS medium, on which MAT-1, MAT-2 sporidia or mixed sporidia (to induce mating and filamentation) were allowed to growth for 3 d before photographing. B: 200 μM JA was add into YePS medium on which mating MAT-1 x MAT-2 culture was confronted with three colonies of pJMT, with or without IPTG induction. The results were observed after 3 d of incubation.
Figure 4.
E. coli pJMT strain suppressed S. scitamineum filamentation under in vitro culture condition. The pJMT strain was able to suppress filamentous growth of S. scitamineum after sexual mating, by supplying the supernatent to the fungal colonies (A), or in confrontation assay (B). A: JA was added in the liquid LB to reach a final concentration of 200 μM, with or without IPTG (1 mM) to induce JMT induction. 4mL supernatant of pJMT culture were mixed with 6 mL YePS medium, on which MAT-1, MAT-2 sporidia or mixed sporidia (to induce mating and filamentation) were allowed to growth for 3 d before photographing. B: 200 μM JA was add into YePS medium on which mating MAT-1 x MAT-2 culture was confronted with three colonies of pJMT, with or without IPTG induction. The results were observed after 3 d of incubation.
Figure 5.
E. coli pJMT applied in controlling maize smut disease in pot experiment. The U. maydis MAT-1 and MAT-2 sporidia (1:1, V/V, OD600≈ 1.0) were mixed, and 1 mL of such mixture was injected to the the stem of four-leaf stage maize seedlings. In the treatment group, U. maydis sporidia mixture was suspended with liquid-cultured pJMT (OD600≈ 1.0). The E. coli strain harboring the vector pRSFDUET-1 served as an untreated control, and the seedlings injected with water as blank control. The tumor symptoms were examined and documented at 21 d post infection.
Figure 5.
E. coli pJMT applied in controlling maize smut disease in pot experiment. The U. maydis MAT-1 and MAT-2 sporidia (1:1, V/V, OD600≈ 1.0) were mixed, and 1 mL of such mixture was injected to the the stem of four-leaf stage maize seedlings. In the treatment group, U. maydis sporidia mixture was suspended with liquid-cultured pJMT (OD600≈ 1.0). The E. coli strain harboring the vector pRSFDUET-1 served as an untreated control, and the seedlings injected with water as blank control. The tumor symptoms were examined and documented at 21 d post infection.
Figure 6.
Black whip symptom of sugarcane smut under pJMT treatment or control condition in the field trail experiment. Ratoons of the canes grown in the diseased field in experimental fields of South China Agricultural University (23.23 E, 113.63 W) were used for testing smut control capacity of pJMT strains. Three plots containing totally approximately 290 seedling, out of 90 clumps, were respectively set as control or pJMT treatment plots. pJMT culture was pre-treated with IPTG before applying to the ratoons within 3 days after cutting the above-ground parts. Disease symptoms, including typical symptom and obvious growth defects of the infected seedlings, were evaluated at three months post growth of ratoons A seedling with typical black whip and slim stem symtoms were displayed in left panel . The disease occurring rate based on the number of black whips were on the right panel. Significant differences in diseased seedlings with the pJMT treatment compared to untreated were determined by a two-tailed Student’s t-test (*p = 0.0165).
Figure 6.
Black whip symptom of sugarcane smut under pJMT treatment or control condition in the field trail experiment. Ratoons of the canes grown in the diseased field in experimental fields of South China Agricultural University (23.23 E, 113.63 W) were used for testing smut control capacity of pJMT strains. Three plots containing totally approximately 290 seedling, out of 90 clumps, were respectively set as control or pJMT treatment plots. pJMT culture was pre-treated with IPTG before applying to the ratoons within 3 days after cutting the above-ground parts. Disease symptoms, including typical symptom and obvious growth defects of the infected seedlings, were evaluated at three months post growth of ratoons A seedling with typical black whip and slim stem symtoms were displayed in left panel . The disease occurring rate based on the number of black whips were on the right panel. Significant differences in diseased seedlings with the pJMT treatment compared to untreated were determined by a two-tailed Student’s t-test (*p = 0.0165).

Table 1.
Primer sequences.
Table 1.
Primer sequences.
| Primer |
Sequence (5’-3’) |
Notes |
| Actin-F |
CAGCTCGATGAAGGTCAAGAT |
qRT-PCR |
| Actin-R |
CAGCTCGATGAAGGTCAAGAT |
| Q-bE1-F |
CCAACGACGAAAGCGCGACG |
| Q-bE1-R |
GACTCTCTGCGAGCGGGCAT |
| Q-bE2-F |
CCAACGACGAAAGCGCGACG |
| Q-bE2-R |
GACTCTCTGCGAGCGGGCAT |
| Q-bW1-F |
CGAGAAAGGCACACAACGTC |
| Q-bW1-R |
CACCTTTTGGGGAGTTCCGA |
| Q-bW2-F |
TGTTGATGAGCCAGTGCCTT |
| Q-bW2-R |
AGTTCCGACTGGCTGAAGTG |
| Pra2-P1F |
GAAGAGCCTCAGCCGTTATAC |
| Pra2-P1R |
GGGTTCCCTTACTGAACCTTAG |
| Q-PCR-Mfa1-F |
ATGCTTTCCATCTTTACCCAGA |
| Q-PCR-Mfa1-R |
GTGCAGCTAGAGTAGCCAAG |
| Mfa2-P1F |
CGTCCAGGCCATTGTTTCT |
| Mfa2-P1R |
TAGGCCACGGTGCAGTA |
| Q-PCR-Pra1-F |
GGACGCTATCACCCAATCTTAC |
| Q-PCR-Pra1-R |
TCTCCAACATGGCAACACTC |
| pJMT-F |
GAATTCATGGAGGTAATGCGA |
Red front denotes restriction enzyme sites used for plasmid construction |
| pJMT-R |
GTCGACTCAACCGGTTCTAAC |